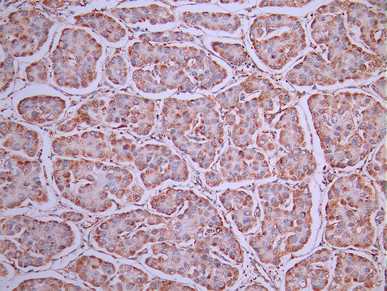

TNFRSF10D Recombinant Monoclonal Antibody
-
中文名稱:TNFRSF10D Recombinant Monoclonal Antibody
-
貨號:CSB-RA160607A0HU
-
規格:¥1320
-
圖片:
-
IHC image of CSB-RA160607A0HU diluted at 1:100 and staining in paraffin-embedded human liver cancer performed on a Leica BondTM system. After dewaxing and hydration, antigen retrieval was mediated by high pressure in a citrate buffer (pH 6.0). Section was blocked with 10% normal goat serum 30min at RT. Then primary antibody (1% BSA) was incubated at 4°C overnight. The primary is detected by a Goat anti-rabbit polymer IgG labeled by HRP and visualized using 0.05% DAB.
-
-
其他:
產品詳情
-
Uniprot No.:
-
基因名:
-
別名:CD 264 antibody; CD264 antibody; DcR 2 antibody; DcR2 antibody; Decoy receptor 2 antibody; Decoy with truncated death domain antibody; OTTHUMP00000123528 antibody; TNF receptor related receptor for TRAIL antibody; TNF related apoptosis inducing ligand receptor 4 antibody; TNF-related apoptosis-inducing ligand receptor 4 antibody; TNFRSF 10D antibody; TNFRSF10D antibody; TR10D_HUMAN antibody; TRAIL R4 antibody; TRAIL receptor 4 antibody; TRAIL receptor with a truncated death domain antibody; TRAIL-R4 antibody; TRAILR4 antibody; TRUNDD antibody; Tumor necrosis factor receptor superfamily member 10D antibody; Tumor necrosis factor receptor superfamily; member 10d; decoy with truncated death domain antibody
-
反應種屬:Human
-
免疫原:A synthesized peptide from human TNFRSF10D protein
-
免疫原種屬:Homo sapiens (Human)
-
標記方式:Non-conjugated
-
克隆類型:Monoclonal
-
抗體亞型:Rabbit IgG
-
純化方式:Affinity-chromatography
-
克隆號:21F5
-
濃度:It differs from different batches. Please contact us to confirm it.
-
保存緩沖液:Rabbit IgG in 10mM phosphate buffered saline , pH 7.4, 150mM sodium chloride, 0.05% BSA, 0.02% sodium azide and 50% glycerol.
-
產品提供形式:Liquid
-
應用范圍:ELISA, IHC
-
推薦稀釋比:
Application Recommended Dilution IHC 1:50-1:200 -
Protocols:
-
儲存條件:Upon receipt, store at -20°C or -80°C. Avoid repeated freeze.
-
貨期:Basically, we can dispatch the products out in 1-3 working days after receiving your orders. Delivery time maybe differs from different purchasing way or location, please kindly consult your local distributors for specific delivery time.
-
用途:For Research Use Only. Not for use in diagnostic or therapeutic procedures.
相關產品
靶點詳情
-
功能:Receptor for the cytotoxic ligand TRAIL. Contains a truncated death domain and hence is not capable of inducing apoptosis but protects against TRAIL-mediated apoptosis. Reports are contradictory with regards to its ability to induce the NF-kappa-B pathway. According to PubMed:9382840, it cannot but according to PubMed:9430226, it can induce the NF-kappa-B pathway.
-
基因功能參考文獻:
- The high-dose hook effect was apparent during ELISA testing of uDcR2 in chronic kidney disease (CKD) patients, yet dilution of the urine samples neutralized this effect. However, the use of a four-fold dilution of urine for uDcR2/cre testing may eliminate the high-dose hook effect and make it possible to effectively monitor the severity of TII in CKD patients. PMID: 29879421
- results suggest that CD264 is a surface marker of cellular age for bone marrow-derived mesenchymal stem cells. PMID: 28962588
- Urinary DcR2 could potentially serve as a novel biomarker for tubulointerstitial injury and may reflect senescence of renal proximal tubular cells in diabetic nephropathy. PMID: 28356293
- Results identified epigenetic inactivation of TNFRSF10C and TNFRSF10D in majority of cervical cancer cases. PMID: 26542757
- membrane expression more common in endometrioid endometrial cancer than in normal endometrium PMID: 24649804
- This study identified TNFRSF10D DNA methylation status as an independent prognostic biomarker for relapse-free survival and overall mortality in non-metastatic melanoma patients. PMID: 25003639
- The membrane expression of the TRAIL receptors DR4, DR5, DcR1 and DcR2 is greater in normal endometrium than endometrioid adenocarcinoma (EAC). The level of the receptors in EAC is not dependent on grading and staging and does not predict survival. PMID: 23584885
- the results presented here claim for a relevant impact of aberrant methylation of decoy receptors in melanoma and allow to understand how the silencing of DcR1 and DcR2 is related to melanomagenesis. PMID: 24211571
- TRAIL receptor-4 expression profiles on T cells might be important in revelation of rheumatoid arthritis pathogenesis. PMID: 20799941
- ANT2 shRNA treatment sensitized MCF7, T47 D, and BT474 cells to TRAIL-induced apoptosis by up-regulating the expression of TRAIL death receptors 4 and 5 (DR4 and DR5) and down-regulating the TRAIL decoy receptor 2 (DcR2). PMID: 20875141
- these results demonstrated that hypoxia-inducible factor 1alpha played a crucial role in regulating the transcription of DcR2. PMID: 20018172
- Enhanced expression of DcR2 promotes peripheral blood eosinophil survival in the airways of allergic asthmatics following segmental antigen challenge. PMID: 12421985
- Cytotoxicity and apoptosis induced by TRAIL to beta-cell lines CM were inhibited competitively by soluble TRAIL receptors, R1, R2, R3 or R4. PMID: 12488957
- Respiratory syncytial virus infection strongly up-regulated the expression of tumor necrosis factor-related apoptosis-inducing ligand (TRAIL) and its functional receptors death receptor 4 (DR4) and DR5. PMID: 12915532
- Our results demonstrate that DcR1 and DcR2 genes are frequently methylated in various tumor types and aberrant methylation was the cause for silencing of DcR1 and DcR2 expression. PMID: 14999791
- The DcR2 was found to have a truncated and non-functional death domain. PMID: 15538968
- CD8+ lymphocytes and NKT lymphocytes, but not CD4+ lymphocytes, express TRAIL-R4 PMID: 15919363
- Resistance to TRAIL-induced apoptosis in acute myeloid leukemia cells is associated with expression of TRAIL-R4. PMID: 15921376
- Preligand assembly domain-mediated ligand-independent association between TRAIL receptor 4 (TR4) and TR2 regulates TRAIL-induced apoptosis. PMID: 16319225
- DCR2 was found positive in 81 and 33% normal, 46 and 10% nodular hyperplasia, 74 and 36% PIN tissues, 87 and 89% low-grade carcinomas, and 100 and 93% high-grade carcinomas PMID: 16799475
- TRAIL-R4-beta is a new splice variant of TRAIL-receptor 4 lacking the cysteine rich domain 1 PMID: 16934748
- The specificity of DcR1- and DcR2-mediated TRAIL inhibition reveals an additional level of complexity for the regulation of TRAIL signaling. PMID: 16980609
- CASP8, DCR2, and HIN-1 methylation leads to progression of neuroblastoma PMID: 17545522
- These data strongly support a recent proposal that a segment at 8p21.3 contains crucial prostate cancer tumor suppressors. PMID: 18460741
- DCR2-methylated patients showed significantly poorer 5-year event-free survival in the whole neuroblastoma group (43% PMID: 18980997
- High TRAIL death receptor 4 and decoy receptor 2 expression correlates with significant cell death in pancreatic ductal adenocarcinoma patients. PMID: 18981952
- Results indicate that disc cells, after herniation, undergo apoptotic cell death via the DR5/TRAIL pathway. PMID: 19730199
顯示更多
收起更多
-
亞細胞定位:Membrane; Single-pass type I membrane protein.
-
組織特異性:Widely expressed, in particular in fetal kidney, lung and liver, and in adult testis and liver. Also expressed in peripheral blood leukocytes, colon and small intestine, ovary, prostate, thymus, spleen, pancreas, kidney, lung, placenta and heart.
-
數據庫鏈接:
Most popular with customers
-
-
YWHAB Recombinant Monoclonal Antibody
Applications: ELISA, WB, IHC, IF, FC
Species Reactivity: Human, Mouse, Rat
-
Phospho-YAP1 (S127) Recombinant Monoclonal Antibody
Applications: ELISA, WB, IHC
Species Reactivity: Human
-
-
-
-
-